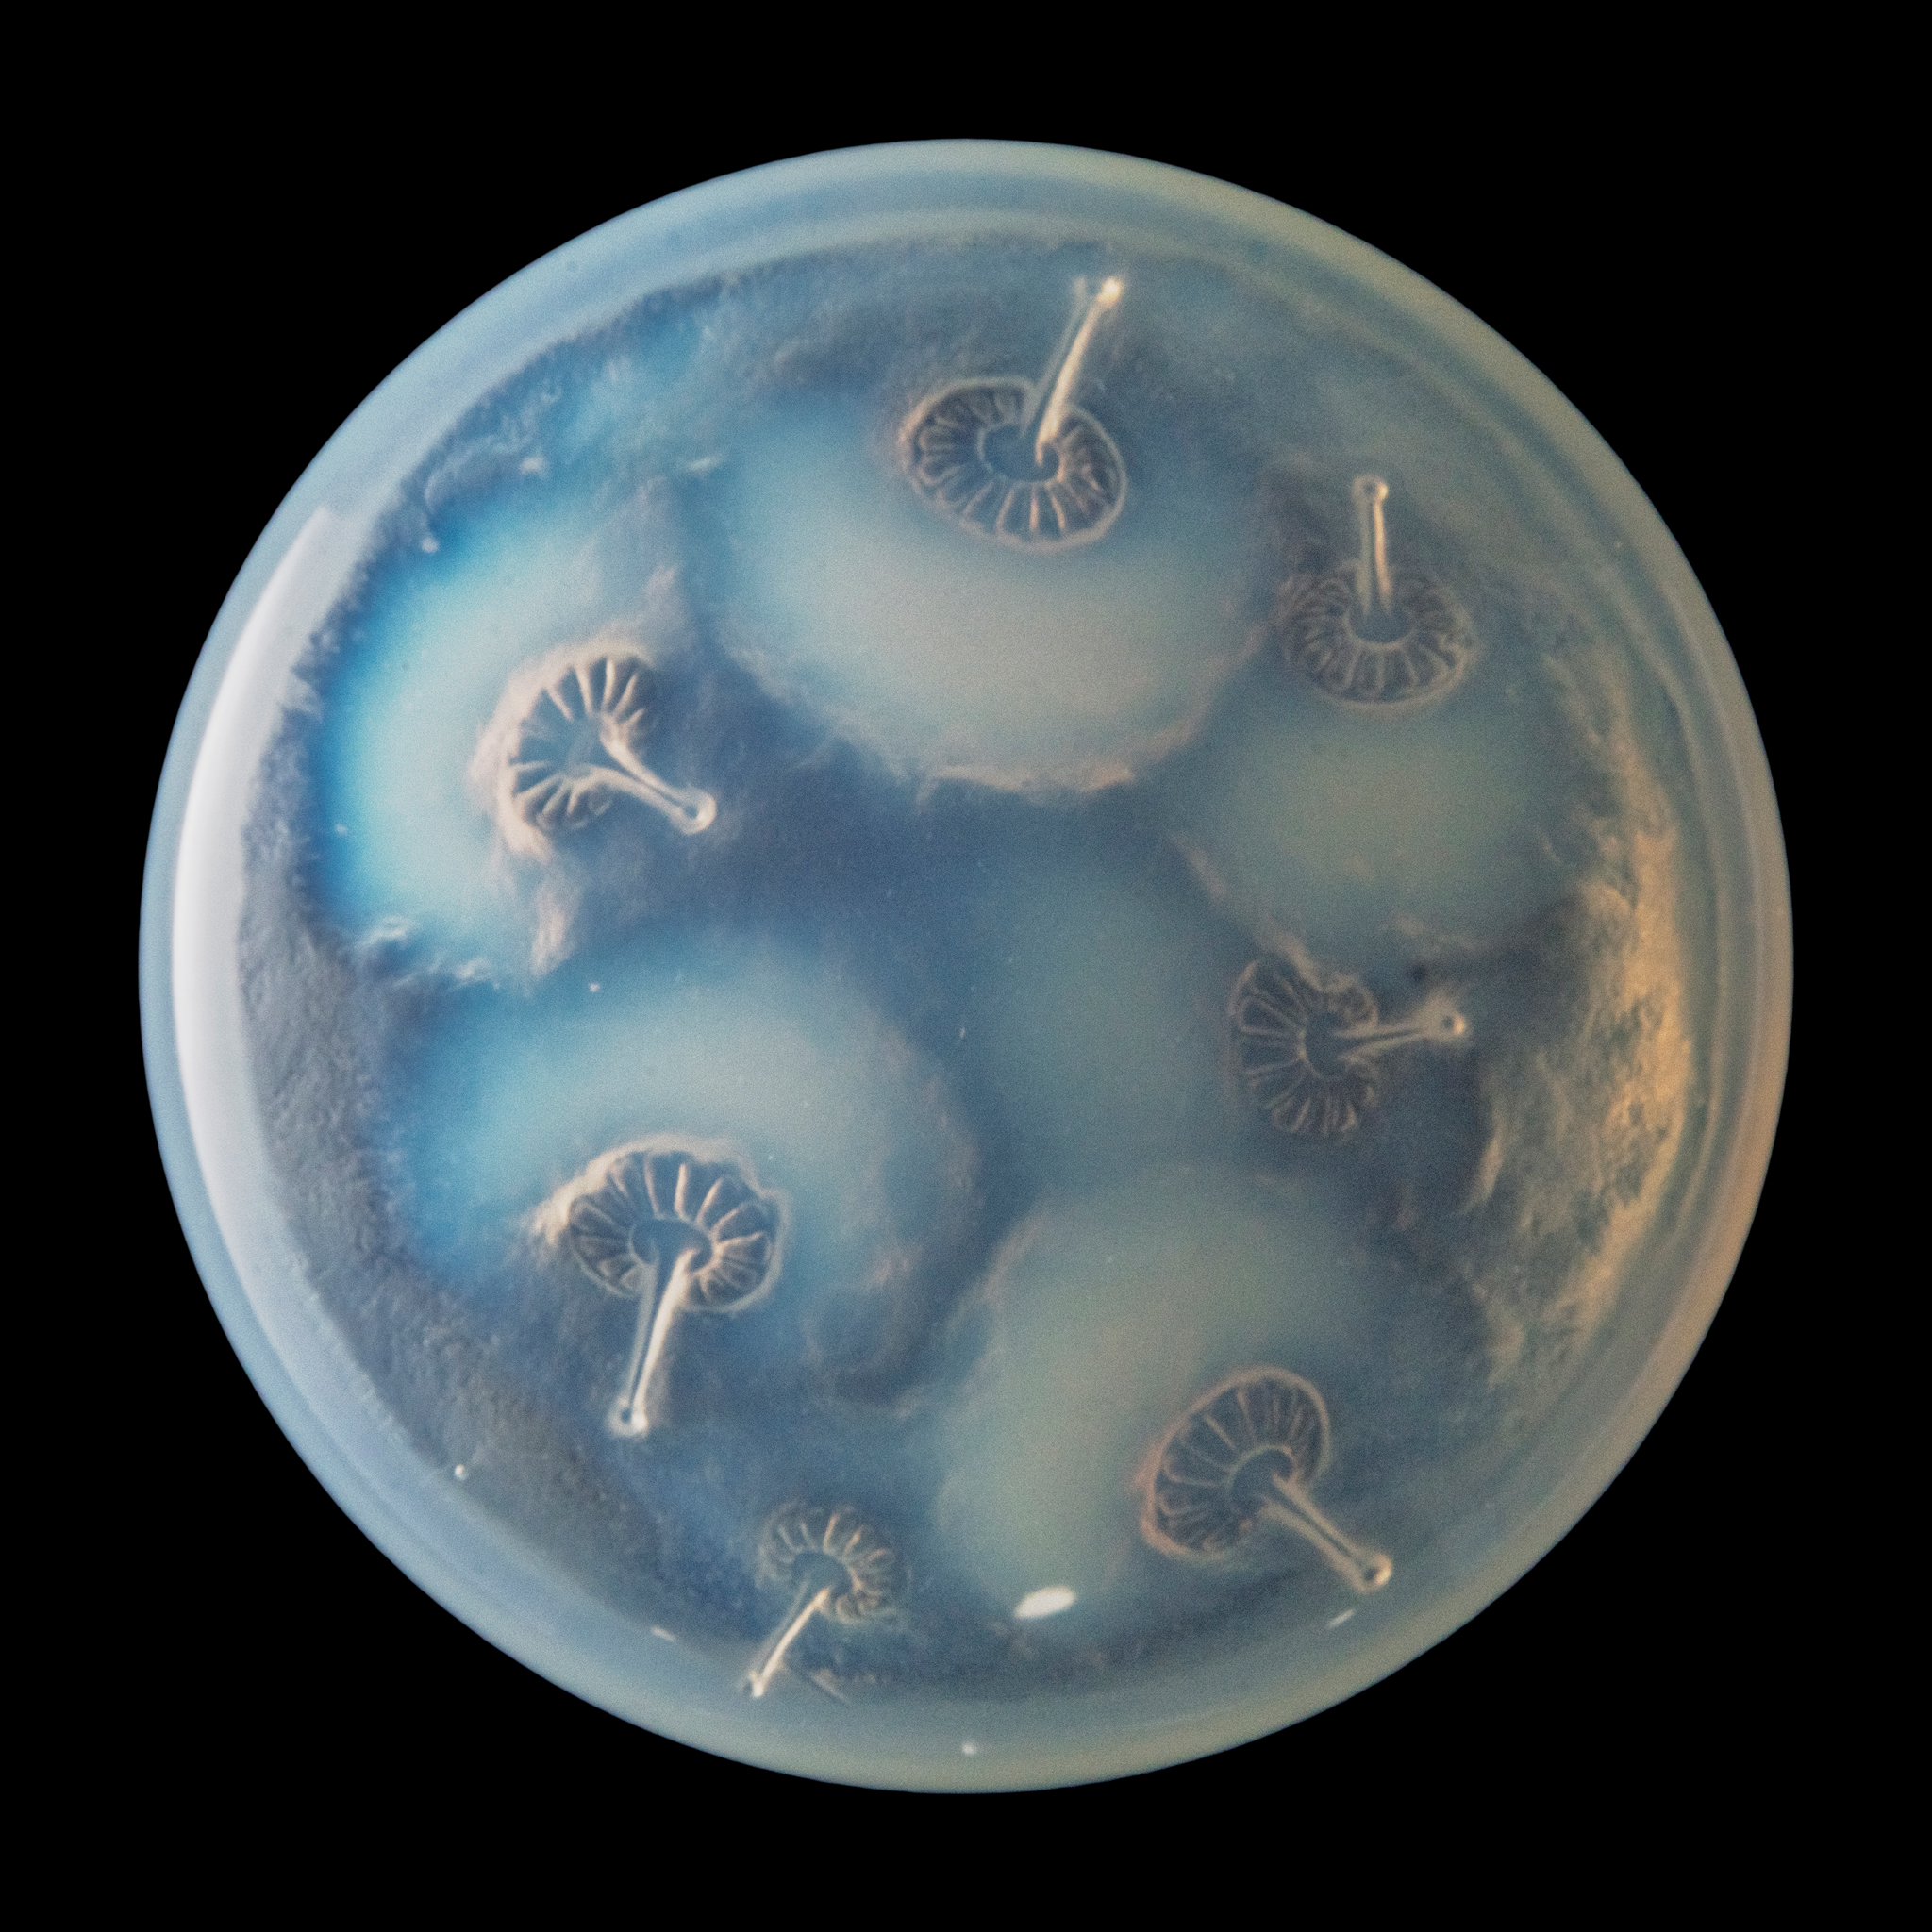
RENÉ LALIQUE (1860-1945)

Lot 36
RENÉ LALIQUE (1860-1945)
HOUPPES BOX, NO. 29











Auction: A Passion for Glass: Lalique from a Private Collection | Lots 1 to 48 | Thurs 30 April 2026 from 1pm
£585
Description
designed 1921
opalescent
moulded R. LALIQUE, base engraved R. Lalique France
(2)
Dimensions
13.9cm diameter
Provenance
A Passion for Glass: Lalique from a Private Collection











